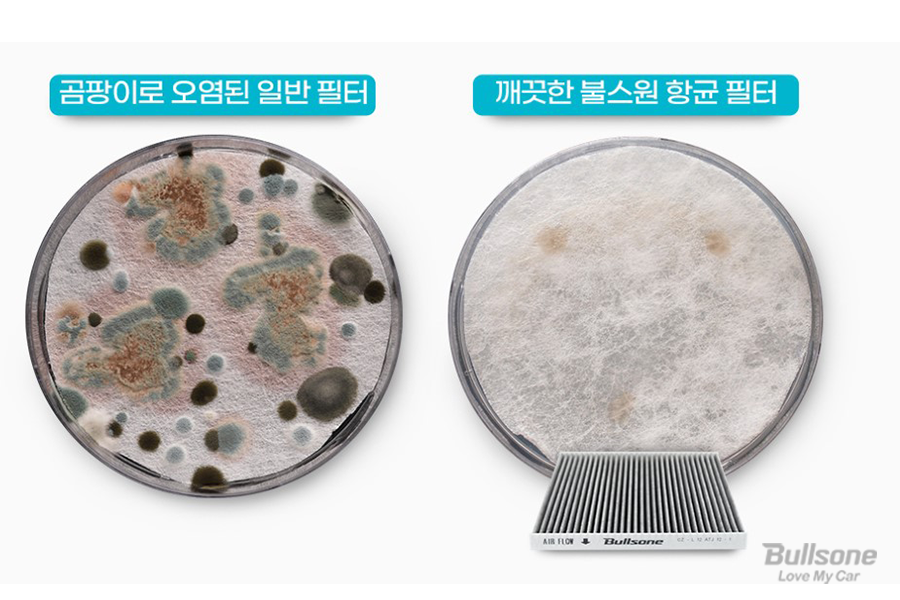

안녕하세요, 불스원입니다.
저번 주말에는 20도를 넘는 온도로 갑자기 여름이 온 듯했는데요. 이럴 때 찾게 되는 에어컨! 에어컨과 히터가 작동하는 주요 장치 중 하나인 자동차 에어컨 옵션은 단순한 습관 하나로도 건강과 연결될 수 있습니다. 오늘은 자동차 에어컨 관리와 중요성에 대해 살펴보겠습니다.

장기간 사용하지 않던 에어컨을 가동하면 시원한 바람 대신 찬 바람이 아니라 심한 악취가 났던 경험, 있으신가요? 이는 바로 곰팡이 때문입니다. 곰팡이는 냄새가 날 뿐만 아니라 차량 탑승자의 건강을 위협하기 때문에 방치해서는 안 되며 즉각적인 조치가 필요합니다. 먼저 에어컨을 본격적으로 가동하기 전에 청소를 통해 곰팡이를 완전히 제거해주어야 합니다.
또한 외부의 공기가 들어올 수 있도록 주기적으로 외부순환 모드를 사용하는 것도 중요합니다. 내부순환 모드만 사용할 경우 차량 내부로만 공기가 순환해 오히려 악취를 유발할 수 있기 때문입니다. 또한, 목적지에 도착하기 전 에어컨을 끄고 증발기의 물기를 말려주는 습관을 들이는 것도 도움이 됩니다. 도착하기 2~3분 전에 에어컨을 끄고 풍량 조절 다이얼을 시계 방향으로 2~3칸 이동하면 습기와 냄새를 예방하고 연료도 절약할 수 있습니다.

자동차 에어컨 악취를 없애기 위해서는 정기적인 에어컨 필터 교체가 무엇보다 중요하겠죠! 냄새제로 항균 활성탄 필터는 기존 냄새제로 에어컨 히터 필터에서 리뉴얼 된 제품으로 냄새, 곰팡이 걱정 없는 항균 코팅막이 추가되었습니다. 원단 등급 업그레이드로 초미세먼지를 99% 차단해줍니다. 제오 액티브 포뮬라와 활성탄 성분이 차량 내 악취, 배기가스, 유해가스를 효과적으로 감소시켜줍니다. 냄새제로 더블 탈취 필터층으로 황사와 꽃가루 등 거대 먼지를 1차로 제거하고, 초미세먼지 제거로 총 2단계 미세먼지 제거 효과를 보여줍니다.
냄새제로 항균 활성탄 필터는 0등급의 항곰팡이 효과를 보여줍니다. 항곰팡이 효과 0등급이란 필터 원단 표면에 오염된 곰팡이에 대한 저항성을 뜻하며,현미경으로 관찰 시 시험편의 접종한 부분에 균사의 발육이 인지되지 않는 최고 등급을 의미합니다. 한국건설생활환경시험연구원에서 같은 크기의 필터 원단에 곰팡이 시험액을 접종하고 4주간 배양한 후 현미경 혹인 육안 판별을 통해 판정한 결과입니다.
시험결과를 보니 불스원 냄새제로 항균 활성탄 필터의 효과가 확연하게 느껴지는데요! 자동차 용품 전문가 필터 전문 연구원이 각종 연구를 바탕으로 수많은 실험과 검증된 테스트를 거쳐 개발한 냄새제로 항균 활성탄 필터를 체험해보세요!

자동차 에어컨 히터 필터의 올바른 교체 주기는 10,000km 주행 또는 교체 후 6개월입니다. 요즘같이 미세먼지가 심한 때에는 3개월마다 에어컨 필터를 교체해주는 것이 좋습니다.
1. 조수석 하단의 글로브 박스를 열어주세요.
2. 글로브 박스 안쪽의 좌우 고정핀을 돌려 분리해주세요.
3. 필터 덮개를 위 아래 또는 좌우로 눌러 분리한 필터를 빼주세요.
4. 새 필터로 교체하고 역순으로 조립하면 교체가 완료됩니다.
오늘은 자동차 에어컨 관리의 중요성, 냄새제로 항균 활성탄 필터와 그 교체법에 대해 알아보았습니다. 본격적인 여름이 시작되기 전에 냄새제로 항균 활성탄 필터로 에어컨 필터 교체하시고 쾌적한 여름 맞이 하시는 건 어떨까요?
